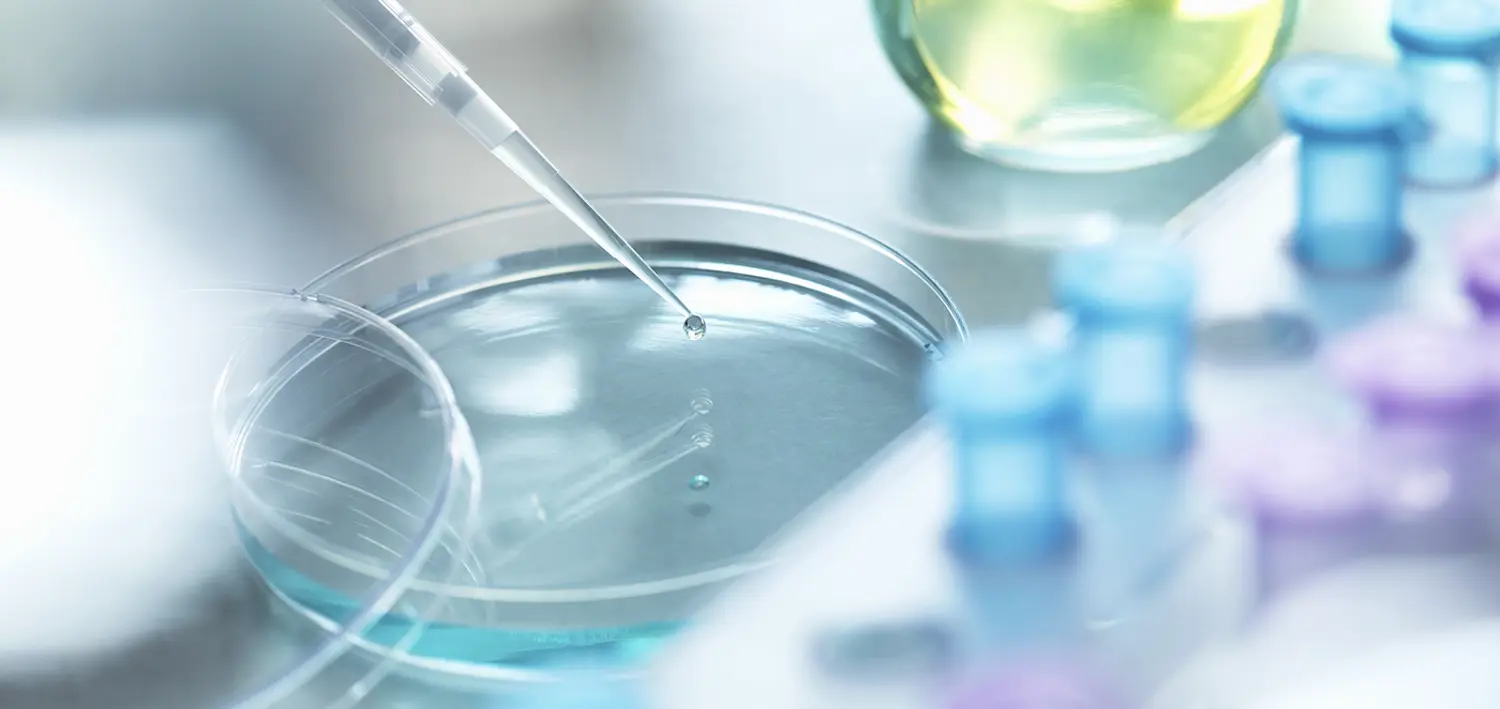

SmartLab 26
Er du opptatt av å ligge i forkant av utviklingen innen labdrift og teknologi? Ta del i fremtidens møteplass for laboratorier!
Få innsikt i laboratorienes fremtid
SmartLab 26 gir deg oversikt over de viktigste trendene som former laboratoriearbeidet fremover. Kunstig intelligens, automatisering, kvalitetsarbeid og bærekraft står sentralt – presentert gjennom konkrete brukercaser og faglige foredrag du faktisk kan ta med deg tilbake til egen hverdag.
Møt fagmiljøet som driver utviklingen
Konferansen samler beslutningstagere, fagspesialister og leverandører fra hele laboratoriebransjen. Her får du mulighet til å utveksle erfaringer, bygge nettverk og diskutere løsninger med kolleger som står overfor de samme utfordringene som deg.
Praktisk, relevant og inspirerende
SmartLab er ikke bare prat om fremtiden – det handler om hva du kan gjøre i dag. Du får konkrete verktøy, nye perspektiver og inspirasjon som bidrar til bedre drift, høyere kvalitet og smartere bruk av teknologi i laboratoriet.
Bygg kompetanse og nettverk!
I samarbeid med ledende fageksperter utvikler vi høyaktuelle, faglige møteplasser for å sikre at du til enhver tid innehar oppdatert kompetanse og et verdifullt nettverk.


